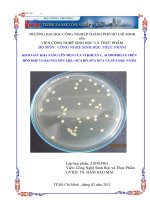
KHẢO SÁT KHẢ NĂNG LÊN MEN CỦA VI KHUẦN L. ACIDOPHILUS TRÊN HỖN HỢP 3 LOẠI NGUYÊN LIỆU SỮA BÒ, SỮA DỪA VÀ SỮA ĐẬU NÀNH

Khảo sát khả năng kháng khuẩn của vi nấm phân lập từ vùng biển nha trang
Bạn đang xem bản rút gọn của tài liệu. Xem và tải ngay bản đầy đủ của tài liệu tại đây (2.71 MB, 72 trang )
i
BỘ GIÁO DỤC VÀ ĐÀO TẠO
TRƯỜNG ĐẠI HỌC NHA TRANG
VIỆN CÔNG NGHỆ SINH HỌC VÀ MÔI TRƯỜNG
----------
ĐỒ ÁN TỐT NGHIỆP ĐẠI HỌC
Ngành Công nghệ sinh học
KHẢO SÁT KHẢ NĂNG KHÁNG KHUẨN CỦA VI NẤM
PHÂN LẬP TỪ VÙNG BIỂN NHA TRANG
Cán bộ hướng dẫn
: ThS. LÊ NHÃ UYÊN
ThS. PHAN THỊ HOÀI TRINH
Sinh viên thực hiện
: PHẠM THỊ THANH
Mã số sinh viên
: 55132666
Lớp
: 55SH2
Nha Trang, tháng 6 năm 2017
ii
BỘ GIÁO DỤC VÀ ĐÀO TẠO
TRƯỜNG ĐẠI HỌC NHA TRANG
VIỆN CÔNG NGHỆ SINH HỌC VÀ MÔI TRƯỜNG
----------
ĐỒ ÁN TỐT NGHIỆP ĐẠI HỌC
Ngành Công nghệ sinh học
KHẢO SÁT KHẢ NĂNG KHÁNG KHUẨN CỦA VI NẤM
PHÂN LẬP TỪ VÙNG BIỂN NHA TRANG
Cán bộ hướng dẫn
: ThS. LÊ NHÃ UYÊN
ThS. PHAN THỊ HOÀI TRINH
Sinh viên thực hiện
: PHẠM THỊ THANH
Mã số sinh viên
: 55132666
Lớp
: 55SH2
Nha Trang, tháng 6 năm 2017
i
LỜI CẢM ƠN
Lời đầu tiên, tôi xin bày tỏ lòng biết ơn sâu sắc tới ThS. Lê Nhã Uyên (Giảng
viên Viện Công nghệ Sinh học và Môi trường – Trường Đại Học Nha Trang) và ThS.
Phan Thị Hoài Trinh (Cán bộ phòng Công nghệ sinh học biển – Viện nghiên cứu và
Ứng dụng công nghệ Nha Trang), những người đã tận tình dìu dắt, hưỡng dẫn tôi
trong suốt quá trình hoàn thành đồ án tốt nghiệp đại học.
Tôi xin gửi lời cảm ơn chân thành đến Ban giám hiệu Trường Đại học Nha
Trang, cùng toàn thể các thầy cô giáo đã tận tình chỉ dạy và cho tôi nhiều kiến thức
quý báu trong suốt bốn năm học qua.
Tôi chân thành cám ơn Ban lãnh đạo Viện Nghiên cứu và Ứng dụng công nghệ
Nha Trang, các anh chị phòng Công nghệ sinh học biển, đặc biệt là chị Ngô Thị Duy
Ngọc đã giúp đỡ nhiệt tình và tạo điều kiện thuận lợi nhất cho tôi thực hiện đồ án này.
Cuối cùng, tôi xin chân thành cảm ơn gia đình, người thân, bạn bè đã luôn quan
tâm, động viên, cổ vũ, giúp đỡ tôi trong quá trình học tập và hoàn thiện đồ án.
Xin chân thành cảm ơn!
Nha Trang, tháng 6 năm 2017
Sinh viên
Phạm Thị Thanh
ii
MỤC LỤC
LỜI CẢM ƠN ......................................................................................................... i
DANH MỤC CÁC BẢNG...................................................................................... iv
DANH MỤC CÁC HÌNH, BIỂU ĐỒ .................................................................... v
MỞ ĐẦU .................................................................................................................. 1
CHƯƠNG 1. TỔNG QUAN .................................................................................. 3
1.1. Tổng quan về vùng nghiên cứu ........................................................................ 3
1.2. Đặc điểm của nấm sợi ....................................................................................... 4
1.2.1. Hình thái, cấu tạo ...................................................................................... 4
1.2.2. Đặc điểm sinh lý, sinh hoá ......................................................................... 6
1.2.3. Phương thức sinh sản ................................................................................. 8
1.2.4. Vai trò của nấm sợi .................................................................................... 9
1.2.5. Phân loại nấm sợi ....................................................................................... 9
1.3. Khả năng hình thành chất kháng sinh từ nấm sợi ............................................ 11
1.3.1. Những đặc điểm cơ bản về chất kháng sinh ............................................... 11
1.3.2. Các yếu tố ảnh hưởng đến khả năng sinh kháng sinh ................................ 11
1.3.3. Khả năng sinh kháng sinh của vi nấm ........................................................ 12
1.3.4. Cơ chế tác dụng của chất kháng sinh ......................................................... 15
1.3.5. Tình hình nghiên cứu chất kháng sinh từ vi nấm biển ............................... 17
1.4. Ứng dụng của chất kháng sinh từ vi nấm biển trong thực tiễn ......................... 19
1.4.1. Điều trị hiện tượng lờn thuốc của vi nấm .................................................. 19
1.4.2. Phòng chống bệnh hại cây trồng ................................................................ 20
1.4.3. Phòng chống côn trùng hại cây trồng ........................................................ 20
CHƯƠNG 2. VẬT LIỆU VÀ PHƯƠNG PHÁP .................................................. 22
2.1. Thời gian và địa điểm nghiên cứu ..................................................................... 22
2.2. Vật liệu, hóa chất và thiết bị nghiên cứu ........................................................... 22
2.2.1. Vật liệu ........................................................................................................ 22
2.2.1.1. Vi nấm biển .......................................................................................... 22
2.2.1.2. Vi sinh vật kiểm định ........................................................................... 22
2.2.2. Hoá chất ..................................................................................................... 22
2.2.3. Dụng cụ và thiết bị ..................................................................................... 23
iii
2.2.4. Các môi trường sử dụng trong nghiên cứu ............................................... 23
2.3. Phương pháp nghiên cứu ................................................................................... 24
2.3.1. Quy trình phân lập vi nấm từ vùng biển Nha Trang .................................. 24
2.3.2. Quy trình sàng lọc các chủng vi nấm biển có khả năng sinh tổng hợp
các chất kháng khuẩn ............................................................................................... 26
2.3.3. Phương pháp định danh vi nấm biển và quan sát vi thể nấm sợi .............. 28
2.3.4. Khảo sát ảnh hưởng của điều kiện lên men lên hoạt tính kháng khuẩn
của vi nấm biển tuyển chọn ...................................................................................... 28
2.3.4.1. Ảnh hưởng của thời gian lên men ...................................................... 28
2.3.4.2. Ảnh hưởng của nồng độ muối trong môi trường lên men .................. 29
2.3.4.3. Ảnh hưởng của pH môi trường lên men .............................................. 29
CHƯƠNG 3. KẾT QUẢ VÀ THẢO LUẬN......................................................... 30
3.1. Kết quả phân lập vi nấm từ mẫu biển thu thập ở vùng biển Nha Trang ........... 30
3.2 Sàng lọc khả năng sinh các chất kháng khuẩn của các chủng vi nấm biển và
tuyển chọn chủng có hoạt tính kháng khuẩn cao...................................................... 36
3.3. Kết quả xác định đặc điểm hình thái và định danh chủng vi nấm biển ............. 40
3.3.1. Đặc điểm hình thái ..................................................................................... 40
3.3.2. Định danh chủng vi nấm biển ..................................................................... 41
3.4. Kết quả khảo sát ảnh hưởng của các điều kiện lên men đến hoạt tính kháng
khuẩn của chủng vi nấm biển tuyển chọn ................................................................ 42
3.4.1. Ảnh hưởng của thời gian lên men .............................................................. 42
3.4.2. Ảnh hưởng của nồng độ muối trong môi trường lên men .......................... 43
3.4.3. Ảnh hưởng của pH môi trường lên men ..................................................... 45
KẾT LUẬN VÀ KIẾN NGHỊ .................................................................................. 47
1. Kết luận................................................................................................................. 47
2. Kiến nghị .............................................................................................................. 47
TÀI LIỆU THAM KHẢO ........................................................................................ 48
PHỤ LỤC ................................................................................................................. 57
iv
DANH MỤC TỪ VIẾT TẮT
VSV
: Vi sinh vật
CKS
: Chất kháng sinh
KS
: Kháng sinh
NS
: Nấm sợi
VSVKĐ
: Vi sinh vật kiểm định
MT
: Môi trường
EA
: Ethyl acetate
KL
: Khuẩn lạc
VK
: Vi khuẩn
DANH MỤC CÁC BẢNG
Bảng 3.1. Danh sách các mẫu sinh vật biển thu nhận tại Nha Trang ....................... 30
Bảng 3.2. Danh sách và đặc điểm hình thái các chủng vi nấm biển được phân
lập từ bọt biển ........................................................................................................... 32
Bảng 3.3. Danh sách và đặc điểm hình thái các chủng vi nấm biển được phân
lập từ rong biển ......................................................................................................... 34
Bảng 3.4. Danh sách và đặc điểm hình thái các chủng vi nấm biển được phân
lập từ trầm tích .......................................................................................................... 35
Bảng 3.5. Danh sách và đặc điểm hình thái các chủng vi nấm biển được phân
lập từ san hô mềm ..................................................................................................... 36
Bảng 3.6. Hoạt tính kháng khuẩn của các chủng vi nấm biển phân lập từ Nha
Trang ... ..................................................................................................................... 37
Bảng 3.7. Thành phần hóa học của thành tế bào đối với vi khuẩn Gram (+) và
Gram (-) ................................................................................................................... 39
Bảng 3.8. Đặc điểm phân loại chủng nấm sợi 01NT.1.1.5....................................... 41
v
DANH MỤC CÁC HÌNH, BIỂU ĐỒ
Hình 1.1. Vị trí lấy mẫu vi sinh vật biển tại Đầm Bấy Nha Trang, Khánh Hòa. ..... 3
Hình 1.2. Các loại sợi nấm ....................................................................................... 5
Hình 1.3. Cấu trúc sợi nấm ....................................................................................... 5
Hình 1.4. Sinh sản hữu tính ở nấm sợi. ................................................................... 9
Hình 1.5. Khuẩn lạc Penicillium kháng tụ cầu vàng S. aureus năm 1928 ............... 13
Hình 1.6. Cơ chế tác dụng của chất kháng sinh ....................................................... 17
Hình 2.1. Sơ đồ quá trình phân lập vi nấm biển. ..................................................... 24
Hình 2.2. Sơ đồ quá trình khảo sát hoạt tính kháng khuẩn của vi nấm biển ........... 26
Hình 3.1. Khuẩn lạc chủng vi nấm biển 01NT.1.1.5 trên môi trường CYA ............ 40
Hình 3.2. Cuống sinh bào tử của chủng nấm biển 01NT.1.1.5. ............................... 40
Hình 3.3. Biểu đồ ảnh hưởng của thời gian nuôi cấy lên khả năng sinh hợp
chất kháng khuẩn của chủng 01NT.1.1.5 ................................................................. 42
Hình 3.4. Biểu đồ ảnh hưởng của nồng độ muối lên khả năng sinh hợp chất
kháng khuẩn của chủng 01NT.1.1.5 ......................................................................... 44
Hình 3.5. Ảnh hưởng của pH lên khả năng sinh hợp chất kháng khuẩn của
chủng 01NT.1.1.5 ..................................................................................................... 45
1
MỞ ĐẦU
Biển là nguồn cung cấp phong phú và đa dạng các chất có hoạt tính sinh học và
hiện đang thu hút sự quan tâm đặc biệt của các nhà khoa học trên thế giới. Đã có rất
nhiều hợp chất được phát hiện từ sinh vật biển sinh sống ở những nơi có điều kiện rất
khắc nghiệt như độ mặn, áp suất cao hơn, nhiệt độ thay đổi, pH [25]. Chính vì thế,
những hợp chất này có những đặc tính vô cùng quý báu, là nguồn tiềm năng cung cấp
dược liệu chữa bệnh cho con người [23],[ 75]. Các hợp chất thu được có hoạt tính sinh
học vô cùng đa dạng bao gồm: tính kháng khuẩn [18],[ 34],[ 38],[ 92]; chống viêm
[69]; gây độc tế bào [51],[ 78]; kháng nấm [44]; kháng virus và kháng u [63],[ 65],[
68].
Trong số các vi sinh vật biển thì vi nấm là nhóm được nghiên cứu nhiều nhất trên
thế giới [18],[ 70],[ 85]. Cụ thể, các nhà khoa học đã phát hiện được hơn 272 hợp chất
tự nhiên mới có nguồn gốc từ vi nấm biển [41]. Theo các tác giả như Pietra (1997)
[73], Rodrigues et al (2000) [83] và Raghukumar et al (1994) [76], vi nấm biển là
nguồn sinh vật có tiềm năng trong việc sinh các hợp chất thứ cấp, chứa một lượng lớn
các enzyme, đặc biệt là một lượng lớn các chất kháng sinh [66],[ 83]. Theo Ebel R
(2010) [50] thì điều này mở ra những hướng nghiên cứu ứng dụng trong y học, trong
phát triển thuốc [53],[ 62] và trong ngành công nghiệp thực phẩm [91].
Ở Việt Nam cũng như các nước đang phát triển, việc lạm dụng thuốc kháng sinh
đã gây nên sự xuất hiện của nhiều chủng vi sinh vật kháng thuốc nên việc điều trị bằng
kháng sinh trở nên rất khó khăn. Vấn đề tìm kiếm chất kháng sinh mới, có nguồn gốc
từ thiên nhiên do các vi sinh vật tiết ra chống lại các vi sinh vật gây bệnh đã lờn thuốc
đang thu hút sự quan tâm của nhiều nhà khoa học, đó là một việc làm vô cùng cấp
thiết và quan trọng [26]. Trong đó có một số lượng lớn chất kháng sinh mới được tìm
thấy từ nấm biển được chứng minh bởi Rateb et al (2011) [79] và Blunt et al (2015)
[39].
Việt Nam là một quốc gia có chiều dài bờ biển hơn 3.200 km, sở hữu một
nguồn tài nguyên biển vô cùng phong phú, đa dạng. Tuy nhiên, việc nghiên cứu và
khai thác lợi ích từ vi nấm biển vẫn còn tương đối mới và chưa thực sự được quan tâm,
đặc biệt là ở vùng biển Nha Trang.
2
Do vậy, trong khuôn khổ luận văn tốt nghiệp này, chúng tôi thực hiện đề tài:
“Khảo sát khả năng kháng khuẩn của vi nấm phân lập từ vùng biển Nha Trang”
Mục tiêu của đề tài
Phân lập và tuyển chọn chủng vi nấm, xác định khả năng kháng khuẩn và điều
kiện lên men tối ưu của chủng vi nấm tuyển chọn.
Nội dung nghiên cứu
- Phân lập vi nấm từ một số mẫu bọt biển, san hô mềm, rong biển và trầm tích thu tại
vùng biển Nha Trang.
- Sàng lọc khả năng kháng khuẩn của các chủng vi nấm phân lập được đối với một số
chủng vi sinh vật kiểm định và tuyển chọn chủng có khả năng kháng khuẩn cao.
- Định danh bằng phương pháp giải trình tự và xác định đặc điểm hình thái của chủng
vi nấm tuyển chọn trên môi trường đặc trưng.
- Xác định điều kiện lên men tối ưu của chủng vi nấm biển tuyển chọn qua các thông
số: Thời gian, nồng độ muối và pH môi trường.
Ý nghĩa khoa học
- Thu nhận thêm thông tin khoa học về một số chủng vi nấm biển thu thập tại vùng
biển Nha Trang, Khánh Hòa.
Ý nghĩa thực tiễn
- Xây dựng quy trình phân lập, xác định khả năng kháng khuẩn và thu nhận hợp chất
kháng khuẩn thô từ vi nấm biển, từ đó định hướng nghiên cứu việc tách chiết các hợp
chất kháng khuẩn để ứng dụng trong thực tế.
3
CHƯƠNG 1. TỔNG QUAN TÀI LIỆU
1.1. Tổng quan về vùng nghiên cứu
Vị trí địa lý thủy văn của Đầm Bấy - Nha Trang, Khánh Hòa.
Khánh Hòa là một tỉnh ven biển miền Trung và nằm trong khu vực nhiệt đới gió
mùa, trong khoảng 11o41’53” - 12o52’12’’ vĩ độ Bắc và 108o40’12’’ - 109o30’00’ kinh
Đông. Độ dài bờ biển xấp xỉ 200 km. Khánh Hòa có khoảng 200 hòn đảo với tổng
diện tích khoảng 600 km2. Các vịnh và đầm phá phân bố liên tục và dọc theo đường bờ
biển Khánh Hòa: Vũng Rô - Đại Lãnh, Vũng Bến Gỏi - Vịnh Vân Phong, Vịnh Bình
Cang, Đàm Nha Phu và Đầm Thủy Triều - Vịnh Cam Ranh. Hệ thống Vịnh góp phần
vào đặc trưng về địa mạo, trầm tích cũng như các yếu tố thủy động lực làm cho vùng
biển Nha Trang phức tạp, đa dạng và phong phú về nguồn lợi vi sinh vật (VSV) [4].
Đầm Bấy là một thủy vực nhỏ nằm ở phía Đông Nam đảo Hòn Tre trong vịnh
Nha Trang. Đầm Bấy có diện tích 132,5 ha, với tổng thể tích nước ở mực nước triều
trung bình khoảng 12.649.842 m3; độ rộng cửa 853 m, độ dài dọc theo trục chính của
đầm 2.368 m, chỗ hẹp nhất 334 m, nơi rộng nhất 1.060 m. Đây là một vùng nước khá
đẹp, yên tĩnh, nước sạch, có bãi cát mịn, sinh thái học đa dạng và độc đáo, là nơi phù
hợp để có thể triển khai các nghiên cứu và thí nghiệm về sinh học, sinh thái và môi
trường biển [19].
Hình 1.1.Vị trí lấy mẫu vi sinh vật biển tại Đầm Bấy Nha Trang, Khánh Hòa.
4
Tốc độ gió trung bình là 2,6 m/s, dao động 2 – 5 m/s. Hệ thống thủy văn động lực
mang tính hỗn hợp. Sóng cao trung bình 0,4 m, độ cao sóng cực đại là 4,0 - 4,5 m, chu
kỳ trung bình 5,5 - 6,0 s. Do địa hình tương đối dốc, nên sóng tác động mạnh, đặc biệt
là vào thời gian từ tháng 9 đến tháng 4 năm sau. Vùng của Vịnh Nha Trang có hiện
tượng nước trồi với tốc độ trồi dưới nước sâu lên đạt giá trị 10-3 cm/s. Hiện tượng này
đã tạo ra những đặc trưng hải dương học, sinh thái học hết sức đặc biệt và thú vị, có
giá trị khoa học và thực tiễn lớn [7].
1.2. Đặc điểm của nấm sợi
Nấm sợi (NS) thuộc nhóm vi nấm, được phân bố khắp nơi: trong đất, trong nước,
trong không khí, trên thực vật, động vật, kể cả trên cơ thể người [9].
Đây là nhóm VSV có cấu tạo dạng sợi có lông tơ, sợi bông, tạo khuẩn ty ở dạng
bột. Màu sắc của NS được xác định bởi các bào tử do nó sinh ra như màu xanh, vàng,
trắng, đen, nâu…[27].
1.2.1. Hình thái, cấu tạo
Hình thái
Trước kia nhiều người hay nhầm lẫn giữa nấm động vật và nấm thực vật. Cho
đến ngày nay thì thấy rằng, nấm không phải là một loại thuộc thực vật và cũng không
phải là động vật. Vì khi quan sát nấm ta thấy một số đặc điểm sau:
- Nấm không có màu xanh lục của lá cây hay không có chất diệp lục, không có khả
năng tự tổng hợp các chất dinh dưỡng cho chính bản thân. Chúng chỉ phát triển được
trên những thức ăn đã có sẵn.
- Nấm là loại sinh vật phát triển thành hình sợi phân nhánh. Những sợi phân nhánh
này phát triển thành từng đám chằng chịt, người ta gọi là khuẩn ty hay hệ sợi nấm khi
phát triển trên môi trường đặc, thường phân ra làm hai loại rõ rệt: khuẩn ty khí sinh và
khuẩn ty dinh dưỡng [33].
Hai loại khuẩn ty này đóng vai trò và nhiệm vụ khác nhau. Khuẩn ty dinh dưỡng
(hay khuẩn ty cơ chất) ăn sâu vào môi trường làm nhiệm vụ như chiếc rễ của cây xanh.
Còn khuẩn ty khí sinh phát triển trên bề mặt môi trường lại đóng vai trò sinh sản là
chủ yếu.
5
Cấu tạo
Cấu tạo cơ thể là một tản (thallus) tức là cơ thể có bộ máy dinh dưỡng chưa phân
hóa thành các cơ quan riêng biệt. Nấm gây bệnh ở động vật thủy sinh thường có cấu
tạo hình sợi phân nhánh, những nấm này sinh trưởng ở đầu mút sợi nấm và phát triển
rất nhanh tạo thành những đám rất chằng chịt gọi là hệ sợi nấm (mycelya). Từng sợi
nấm gọi là khuẩn ty (hyphae) [28].
Cấu tạo của nấm có thể là đơn bào hoặc đa bào. Ở nấm đa bào có hai loại, một
loại giữa các tế bào không có vách ngăn, toàn bộ sợi nấm như một tế bào khổng lồ đa
hạch được gọi là nấm bậc thấp. một loại khác giữa các tế bào có vách ngăn gọi là nấm
bậc cao [1].
Hình 1.2. Các loại sợi nấm.
NS có thành tế bào cấu tạo chủ yếu là chitin và chitosan. Màng tế bào dầy
khoảng 7 μm thành phần chủ yếu là lipit (40%) và protein (38%). Nhân phân hoá,
thường hình tròn, đôi khi kéo dài, đường kính khoảng 2 – 3 μm. Ty thể hình elip, luôn
di động để tham gia vào quá trình hô hấp của tế bào [29].
Hình 1.3. Cấu trúc sợi nấm.
6
1.2.2. Đặc điểm sinh lý, sinh hoá
Sinh lý
NS có thể phát triển liên tục trong 400 năm hay hơn nếu các điều kiện môi
trường đều thích hợp cho sự phát triển của chúng. Hầu hết các loài NS không cần ánh
sáng trong quá trình sinh trưởng. Tuy nhiên, có một số loài lại cần ánh sáng trong quá
trình tạo bào tử. Nhiệt độ tối thiểu cần cho sự phát triển là 20oC, và nhiệt độ tối đa mà
chúng có thể chịu đựng được là 35oC đến 40oC, cá biệt có một số ít loài có thể sống sót
ở 0oC và ở 60oC. Nói chung, NS có thể phát triển tốt ở môi trường acid (pH = 6)
nhưng pH tối hảo là 5 – 6.5 một số loài phát triển tốt ở pH < 3 và một số ít phát triển ở
pH > 9 [8].
NS có thể sử dụng những nguồn thức ăn cacbon rất khác nhau. Để thực hiện các
quá trình sinh lí khác nhau NS thường có những nhu cầu không giống nhau về các
nguồn thức ăn cacbon. Sự thích hợp của một nguồn gốc thức ăn cacbon nào đó có thể
được đánh giá bằng nhiều chỉ tiêu khác nhau như mức độ sinh trưởng tối đa của hệ sợi
nấm, mức độ hình thành tối đa số lượng bào tử, mức độ tích lũy tối đa các chất chuyển
hoá. Sự sinh trưởng tối đa của hệ sợi nấm thường không phù hợp với sự tích lũy tối đa
các sản phẩm trao đổi chất. Hầu hết các loại NS có thể đồng hoá trực tiếp mantose,
lactose, melibiose, rỉ đường. Ngoài các nguồn Nitơ vô cơ, nấm sợi còn có thể sử dụng
tốt nhiều nguồn Nitơ hữu cơ như protein, pepton, peptide, acid amin…[5],[ 8].
Oxi cũng cần cho sự phát triển của NS vì chúng là nhóm hiếu khí bắt buộc và sự
phát triển sẽ ngưng khi không có oxi [9].
Nguồn dưỡng chất cần thiết cho nấm được xếp theo thứ tự sau: C, O, H, N P, K,
Mg, S, B, Mn, Cu, Zn, Fe, Mo và Ca. Các nguyên tố này hiện diện trong các nguồn
thức ăn vô cơ đơn giản như glucose, muối ammonium... sẽ được nấm hấp thu dễ dàng,
nếu từ nguồn thức ăn hữu cơ phức tạp nấm sẽ sản sinh và tiết ra bên ngoài các loại
enzyme thích hợp để cắt các đại phân tử này thành những phân tử nhỏ để dể hấp thu
vào trong tế bào.
Ngoài các chất dinh dưỡng NS cũng như tất cả các sinh vật khác còn có nhu cầu
về nước cho các hoạt động sinh lý, sinh hóa của tế bào. Liên quan đến lượng nước còn
7
có độ ẩm. Các yếu tố này ảnh hưởng đến chất lượng sản phẩm và quá trình sinh
trưởng, phát triển của chúng (độ ẩm không khí không thấp hơn 60%) [8].
Sinh hóa [8]: Bao gồm một số chất có hoạt tính:
- Hoạt tính sinh các chất kháng sinh (CKS):
CKS là những sản phẩm hữu cơ tự nhiên có khối lượng phân tử thấp được các
VSV tiết ra ở nồng độ thấp nhưng có tác dụng chống lại các VSV khác một cách hữu
hiệu.
CKS là một trong số những sản phẩm trao đổi chất thứ cấp do NS tiết ra. Vai trò
của kháng sinh đối với đời sống là một vấn đề đang được nghiên cứu. Tuy nhiên, có
hai giả thuyết về vai trò của CKS được nhiều nhà khoa học ủng hộ. Giả thuyết thứ nhất
cho rằng việc tổng hợp các CKS nhằm tạo ra ưu thế phát triển cạnh tranh có lợi cho
chủng sinh kháng sinh, nhờ đó chúng có thể tiêu diệt hay kìm hãm sự phát triển của
các loài khác cùng tồn tại và phát triển trong hệ sinh thái cục bộ đó. Giả thuyết thứ hai
cho rằng việc tổng hợp CKS là một đặc tính cần thiết và đảm bảo cho khả năng sống
sót cao cho chủng sinh ra CKS trong tự nhiên, nhất là với các loài có bào tử. Người ta
đã xác định được một số CKS có tác dụng ức chế sự nảy mầm của bào tử của chính
chủng sinh ra CKS đó. Có thể CKS có vai trò kìm hãm sự nảy mầm của bào tử cho
đến khi điều kiện môi trường ngoài hoàn toàn thích hợp cho sự phát triển của chúng.
Đối với con người, CKS là một trong số những sản phẩm có giá trị và ngày càng
trở nên rất quan trọng trong đời sống như: trong việc chữa bệnh, bảo vệ cây trồng, bảo
quản thực phẩm và trong chăn nuôi. Những NS có khả năng sinh CKS mạnh là các
nấm thuộc chi Penicillium, Aspergillus, Cephalosporium, Trichoderma…
- Độc tố nấm:
Độc tố nấm (mycotoxin) cũng là một sản phẩm trao đổi chất thứ cấp của nấm.
Đây là một trong số những mối nguy hại lớn cho sức khỏe con người và động vật khi
sử dụng thức ăn có chứa một hàm lượng độc tố nấm nhất định. Hiện có trên 300 loại
độc tố nấm đã được con người phát hiện. Trong số đó nguy hiểm nhất là aflatoxin, đặc
biệt là aflatoxin B1 [2].
8
Với những đặc điểm quan trọng trên, NS đang trở thành đối tượng rất được quan
tâm nghiên cứu nhằm khai thác triệt để những đặc tính sinh học có lợi phục vụ cho đời
sống con người.
1.2.3. Phương thức sinh sản
NS có nhiều hình thức sinh sản khác nhau:
- Sinh sản sinh dưỡng tạo nên các phân sinh bào tử. Đó là các tế bào sinh trưởng ở
đầu mút của khuẩn ty, có vách tế bào dày lên hình thành các tế bào màng dày, các
hạch nấm. Các tế bào màng dày này đứt ra khỏi cơ thể mẹ và phát triển thành sợi nấm
mới [30].
- Sinh sản vô tính: các bào tử vô tính khác nhau ở hình thái và nguồn gốc phát sinh.
Căn cứ vào đặc điểm phát sinh người ta phân thành bào tử kín và bào tử trần. Một
dạng bào tử vô tính khác không phải là dạng sinh sản được gọi là bào tử màng dày hay
bào tử áo. Chúng do một đoạn sợi nấm tích lũy nhiều chất dinh dưỡng và có thành tế
bào dày lên mà tạo thành nhằm mục đích thích ứng với các điều kiện bất lợi của môi
trường. Một kiểu bào tử vô tính khác nữa đó là bào tử có roi có khả năng bơi lội trong
nước, người ta gọi là bào tử di động [33].
- Sinh sản hữu tính: Nấm hình thành các túi giao tử (gamentagia). Túi giao tử đực gọi
là hùng khí (antheridium), túi giao tử cái gọi là noãn khí (oogonium). Trên khuẩn ty
thường quan sát thấy những cơ quan sinh sản đực và cái của nấm nằm vuông góc với
sợi nấm. Túi giao tử đực nhỏ, thường có hình ống và túi giao tử cái thường là mép túi
phình to dạng hình cầu. Một số giống nấm sinh sản hữu tính theo hình thức tiếp hợp,
túi giao tử đực uốn cong và bao lấy túi giao tử cái, giữa chúng xuất hiện cầu nối
nguyên sinh chất. Qua cầu nối này giao tử đực và cái gặp nhau tạo thành hợp tử. Hợp
tử này nảy mầm phát triển thành sợi nấm mới [30] (Hình 1.4).
9
Hình 1.4. Sinh sản hữu tính ở nấm sợi.
1.2.4. Vai trò của nấm sợi [28],[ 30]
- NS góp phần quan trọng trong việc đảm bảo các vòng tuần hoàn vật chất trong tự
nhiên, phân giải các hợp chất hữu cơ phức tạp.
- Thu nhận nhiều hợp chất có hoạt tính quan trọng được ứng dụng rộng rãi trong công
nghiệp chế biến thực phẩm (sản xuất tương, nước chấm, đậu phụ, cồn, rượu, các acid
xitric, acid gluconic…), tích lũy vitamin, các chất sinh trưởng và nhiều loại ancaloit có
giá trị chữa bệnh, xử lý ô nhiễm môi trường.
- NS có khả năng tiết CKS có giá trị (Penicillium, xephalosporum, fuzidin, fumagilin,
tripaxidin), sản xuất thuốc trừ sâu sinh học, các chất kích thích yếu tố sinh trưởng thực
vật, tăng độ phì nhiêu cho đất, định lượng các chất hoạt động sinh học.
1.2.5. Phân loại nấm sợi
Vi nấm là thuật ngữ dùng để chỉ tất cả các loại nấm hiển vi, không sinh quả thể
lớn (mũ nấm). Việc phân loại vi nấm nói chung và nấm sợi nói riêng vẫn đang ở thời
kì phân loại học hình thái dựa vào các đặc điểm hình thái nuôi cấy, một số đặc điểm
sinh lý sinh hóa và phương thức sinh sản. Các phương pháp sinh hóa và sinh học phân
tử được sử dụng ít trong phân loại vi nấm.
Nhà nấm học Italia P.A. Saccardo (1845-1920) đã chỉnh lý các nghiên cứu về
nấm và biên soạn bằng tiếng La Tinh 25 tập Kỷ yếu nấm. Các thành tựu nghiên cứu đã
được tổng kết khá đầy đủ trong 5 tập sách Giới nấm (The Fungi) của G.C. Ainsworth
và cộng sự (Vol 1, 2, 3, 4A, 4B. New Yord and London: Academic Press, 1963-1973).
10
Năm 1995 đã tái bản lần thứ 8 cuốn từ điển về nấm (Dictionary of the Fungi) của
Ainsworth và Bisby. Nấm được chia thành 4 ngành (Division, Phylum):
- Ngành Chytridiomycota
- Ngành Zygomycota
- Ngành Ascomycota
- Ngành Basidiomycota
Khoá phân loại đến lớp Ngành/Lớp
- Zygomycota (Zygomycetes): nấm hợp tử
- Ascomycota (Ascomycetes): nấm túi
- Basidiomycota (Basidomycetes): nấm đảm
- Deuteromycota (Deuteromycetes): nấm bất toàn.
Theo hệ thống phân loại căn cứ vào đặc điểm phát sinh của bào tử trần của Hughes
(1953). Lớp nấm bất toàn được chia thành 3 nhóm:
Nhóm Hyphomycetes: Gồm các nấm bất toàn không có túi giá và đĩa giá (giá
sinh bào tử trần ở trên các sợi nấm hoặc các sợi nấm kết lại thành bó sợi, bó giá).
Nhóm Coelomycetes: Gồm các nấm bất toàn có túi giá hoặc đĩa giá, giá bào tử
trần ở trong các thể quả (Fruit - body) gọi là các conidiomata [17].
Nhóm Agonomycetes: Gồm các nấm bất toàn không có bào tử trần
Người ta cho rằng trong tự nhiên có khoảng 1 triệu đến 1,5 triệu loài nấm nhưng
mới định tên được khoảng 10 000 chi và 70 000 loài, Trung Quốc đã điều tra được 40
000 loài. Riêng các loài nấm thuộc Nấm bất toàn ở nước ta hiện mới chỉ phát hiện
được 338 loài thuộc 306 chi khác nhau [8]. Bảo tàng giống chuẩn vi sinh vật (VTCC)
thuộc Trung tâm Công nghệ sinh học Đại học Quốc gia Hà Nội hiện đang hợp tác với
Viện NITE (Nhật Bản) điều tra nghiên cứu khu hệ vi nấm ở Việt Nam và có nhiều khả
năng tìm thấy những loài mới trong quá trình nghiên cứu.
Hiện tồn tại nhiều hệ thống phân loại nấm không thống nhất với nhau, có nhiều
khóa phân loại đã được sử dụng như: Saccardo P A (1880- 1886), Barron G.L (1968)
Barnett H.L và cộng tác viên (1972), Ainsworth G C (1973), V.Arx (1981), Bùi Xuân
Đồng (1984) [10], Alexopoulos & Mins (1996), Nguyễn Lân Dũng (2000) [11], Đặng
Hồng Miên (1999) [24], Nguyễn Đức Lượng (2003) [20], Persoon ex Gray (1801). Sự
11
phân loại vi nấm đang ở thời kỳ phân loại học hình thái (Phenetic clasifications) và đã
bắt đầu dựa vào sự phát triển của sinh học phân tử.
Trong luận văn này, chúng tôi dựa vào đặc điểm mô tả trong các khóa phân loại:
Nguyễn Lân Dũng (2000) [11] (trong tài liệu này có khóa phân loại của Saccardo PA
(cải tiến), Barnett H.L và cộng tác viên (1972), Bùi Xuân Đồng (1984) [10], Nguyễn
Đức Lượng (2003) [20], Đặng Hồng Miên (1999) [24].
1.3. Khả năng hình thành chất kháng sinh từ nấm sợi
1.3.1. Những đặc điểm cơ bản về chất kháng sinh
Kháng sinh (antibiotics) là bất kỳ sản phẩm vi sinh nào mà ngay ở nồng độ thấp
(µg/ml) cũng có khả năng ức chế hoặc tiêu diệt các VSV khác (vi khuẩn, nấm men,
nấm mốc…) một cách chọn lọc [2],[ 15].
CKS là một trong các sản phẩm trao đổi chất thứ cấp quan trọng nhất, là nhóm
hợp chất thiên nhiên đa dạng về thành phần hóa học. Chúng có thể là một chất kiềm,
axit, trung tính, dễ bay hơi hay một polypeptit, sản phẩm này có thể tiết ra ngoài môi
trường sống hay tích luỹ trong tế bào. Trước đây việc sử dụng CKS trong điều trị các
bệnh nhiễm trùng thường có nguồn gốc từ VSV (như vi khuẩn, nấm, xạ khuẩn).
Những năm gần đây với những tiến bộ về khoa học kỹ thuật, nhiều CKS đã được tạo
ra theo con đường bán tổng hợp (ampixillin) hoặc tổng hợp mới hoàn toàn
(chloramphenicol) [12].
1.3.2. Các yếu tố ảnh hưởng đến khả năng sinh kháng sinh [26]
Trong quá trình sống, cơ thể VSV thường xuyên trao đổi chất với môi trường
ngoài tạo ra các sản phẩm trao đổi chất khác nhau. Sản phẩm trao đổi chất sơ cấp là
những sản phẩm cần thiết cho sự sống của tế bào, chúng là những vật chất tham gia
xây dựng tế bào như các axít amin, vitamin, nucleotide. Sản phẩm trao đổi chất thứ
cấp là những sản phẩm về mặt hóa học là những hợp chất có cấu tạo cực kỳ phức tạp,
chúng không có chức năng rõ ràng trong trao đổi chất của tế bào như chất kháng sinh,
giberelin, độc tố nấm, các polysacarit.
Quá trình tổng hợp CKS chịu ảnh hưởng của nhiều nhân tố trong đó có thành
phần môi trường (nguồn cacbon, nito, nguyên tố vi lượng, phương pháp nuôi cấy, tuổi
12
giống, độ thông khí…) và điều kiện nuôi cấy. Vì vậy khi nuôi cấy chúng ta tìm điều
kiện tối ưu cho các yếu tố trên để hiệu suất tổng hợp CKS cao nhất.
Cacbon: Quá trình sinh trưởng và sinh tổng hợp CKS chịu ảnh hưởng sâu sắc của
nguồn thức ăn. Tùy thuộc vào từng chủng mà cần chọn nguồn cacbon thích hợp như
các loại đường đơn như glucose, manitol, các loại đường kép như saccarose, lactose,
cũng có thể là các loại đường đa như tinh bột hoặc các chất có thành phần không xác
định như rỉ đường [13].
Nguồn nitơ và nồng độ nitơ trong môi trường nuôi cấy cũng ảnh hưởng lớn đến
sự sinh tổng hợp CKS. Sự dư thừa các ion amin hoặc các nitơ chuyển hóa nhanh khác
sẽ ức chế sinh tổng hợp CKS. Quá trình sinh tổng hợp CKS ở NS thường cần cả 2
nguồn nitơ hữu cơ và vô cơ trong môi trường.
Photphat vô cơ cũng là một trong những yếu tố điều chỉnh sự tổng hợp CKS.
Nồng độ photphat thích hợp cho sinh tổng hợp CKS không quá 10 mg/ml. Nồng độ
photphat ban đầu cao sẽ làm tăng lượng acid nuclêic trong tế bào, làm kéo dài pha sinh
trưởng, rút ngắn pha tổng hợp, làm tăng ATP trong tế bào dẫn đến giảm hoặc ngừng
hẳn sinh tổng hợp CKS. Ngoài ra sự dư thừa photphat cũng ức chế tổng hợp các
enzyme tham gia vào quá trình tổng hợp CKS.
Nhiệt độ tối ưu cho sinh tổng hợp CKS thường trong khoảng từ 28 - 30oC.
Sinh tổng hợp CKS phụ thuộc đáng kể vào pH môi trường, pH thích hợp cho
việc tổng hợp CKS là trung tính, pH acid hay kiềm đều ức chế quá trình tổng hợp
CKS.
Ngoài ra tuổi của giống, khả năng đồng đều về mặt di truyền, hoạt tính trao đổi
chất cũng ảnh hưởng đến khả năng tổng hợp CKS.
1.3.3. Khả năng sinh kháng sinh của vi nấm
Nấm sợi là một trong những VSV có khả năng sinh kháng sinh đầu tiên có ý
nghĩa quan trọng về mặt lịch sử lẫn y học. Bệnh truyền nhiễm trước đây trong một thời
gian dài đã là mối đe dọa rất lớn đối với con người và các VSV khác. Do vậy việc tìm
kiếm thuốc chữa bệnh cho con người, từ lâu đã là mơ ước của nhiều nhà khoa học nói
riêng và của nhân loại nói chung. Và đã có nhiều CKS đã được phát hiện từ nấm sợi
như:
13
Penicillin:
Vào mùa thu năm 1928, tại St Mary’s Hospital London, Alexander Fleming -
một nhà vi sinh vật học trở lại phòng thí nghiệm sau thời gian nghỉ hè. Quan sát các
hộp nuôi VSV cũ còn sót lại trên bàn, ông phát hiện một hộp cấy tụ cầu
Staphylococcus bị nhiễm vi nấm Penicillium sp., và lấy làm ngạc nhiên vì nấm đã ức
chế sự phát triển của tụ cầu. Fleming nhận thức ngay hiện tượng mới lạ này và sau một
loạt thử nghiệm đã thấy nấm Penicillium sp. ức chế sự phát triển của nhiều vi khuẩn
gây bệnh như:
- Liên cầu khuẩn Streptococcus (thường trú ở họng).
- Phế cầu khuẩn Diplococcus pneumoniae gây viêm phế quản, viêm phổi, viêm tai
mũi họng.
- Vi khuẩn bạch hầu Corynebacterium diphteriae.
- Cả xoắn khuẩn giang mai Treponema pallidum lây lan qua đường tình dục. Ông đặt
tên hoạt chất được chiết từ nấm là Penicillin. Nhưng sau đó, công trình của Fleming đã
bị lãng quên. Cho đến chiến tranh thế giới thứ hai, do sự nỗ lực hợp tác của nhiều nhà
khoa học Anh- Mỹ, đứng đầu là Abraham, Chain, Florey thí nghiệm của Fleming đã
được lặp lại, đồng thời đã tiến hành chiết rút thành công và khẳng định giá trị to lớn
của Penicillin “loại thuốc thần kỳ” này đã mở ra một kỷ nguyên mới - kỷ nguyên
kháng sinh trong lịch sử y học của loài người. Chất kháng sinh penicillin được phát
hiện tình cờ vào năm 1928,
Hình 1.5. Khuẩn lạc Penicillium kháng tụ cầu vàng S. aureus năm 1928.
14
Năm 1938, ở Oxford, Ernst Boris Chain và Norman Heatley đưa Penicillium vào
sản xuất thử. Và chỉ sau hai năm đã tinh chế một lượng lớn penicillin, đủ để thử
nghiệm trên chuột thí nghiệm và kết quả điều trị đã thành công mỹ mãn, ngày
25/05/1940 [21].
Năm 1940, Dorothy Hodgkin xác định được cấu trúc phân tử của Penicillin.
Năm 1942, Mary Hunt tìm ra chủng Penicillium chrysogesrum có khả năng sinh
tổng hợp kháng sinh cao gấp hai lần giống Penicillium notatum tìm ra trước đó.
Mãi đến năm 1945, ông mới được nhận giải thưởng Nobel.
Năm 1946 – 1950, hàng loạt chất kháng sinh đã được phát hiện, hàng loạt nhà
máy sản xuất kháng sinh ra đời, chủ yếu là Penicillin, khẳng định giá trị to lớn của
Penicillin sử dụng trong chữa bệnh.
Cephalosporin
Cephalosporin là một họ các CKS được tách lần đầu tiên vào năm 1948 từ nấm
Cephalosporium và cấu trúc betalactam của chúng rất giống cấu trúc của penicilin [3].
Đây là CKS có hoạt tính và cấu tạo gần giống với penicilin nhưng nó lại có khả năng
chống được cả vi khuẩn Gram (+) và vi khuẩn Gram (-) tuy nhiên hoạt tính nó kém
hơn penicilin [14].
Các Cephalosporin gồm có cephalotin, cefoxitin, ceftriaxon và cefoperazon.
Cefoperazon đề kháng với sự huỷ hoại bởi các β-lactamaza và chống lại có hiệu quả
nhiều loại vi khuẩn Gram (-) kể cả Pseudomonas aeruginosa. Cephalexin và cefixim
được uống qua đường miệng chứ không được tiêm [3].
Tetracyclin
Các tetraxyclin là một họ các CKS có một cấu trúc chung gồm bốn vòng mà
hàng loạt các chuỗi bên được gắn vào. Có những CKS phổ biến như: oxitetraxyclin,
clotetraxyclin,… các CKS này ức chế tổng hợp protein bằng cách liên kết với đơn vị
nhỏ (30S) của ribosome và ức chế sự liên kết của các phân tử aminoaxyl – tRNA vào
vị trí A của ribosome [3].
Các Tetracyclin là các CKS phổ rộng (các VK Gram (+) và Gram (-), Rickettsia,
xoắn khuẩn...). Chỉ định điều trị bằng cách kết hợp với các kháng sinh khác để điều trị
các bệnh: Brucella, tả, sốt định kỳ, lậu cầu, giang mai, viêm đường tiêu hoá, sốt rét...
15
Griseofulvin:
Năm 1959, Oxford và cộng sự phát hiện Griseofulvin chiết được từ một số loài
NS thuộc giống Penicilium (P.urticae, P.nigricans, P.raistrichi...). Griseofulvin không
có hoạt tính chống vi khuẩn (VK) nhưng có khả năng chống nấm khá mạnh nên dùng
để chữa bệnh nấm cho người và gia súc [21].
Glytoxin
Glytoxin là CKS từ giống Trichoderma viride, ngoài ra người ta còn phát hiện ở
Aspergillus fumgitus, một vài loài penicilium. Glytoxin không bền vững và bị phân
hủy nhanh trong ánh sáng. Phổ kháng sinh của nó chống các vi khuẩn Gram (+) và các
nấm gây bệnh. Trong kết quả thực nghiệm glytoxin không thể hiện hiệu quả chống
nhiễm trùng lao ở chuột, không ngăn cản sự phát triển của u ác tính. Hoạt tính KS của
glytoxin liên quan với sự có mặt trong phân tử là nhóm chứa lưu huỳnh.
1.3.4. Cơ chế tác dụng của chất kháng sinh
Cơ chế tác dụng của CKS là những cách thức mà CKS tác động lên những vị trí
đích khác nhau trong tế bào, qua đó ảnh hưởng đến sự sinh trưởng của VSV. Sự tác
động của các CKS lên tế bào vi sinh vật phụ thuộc vào bản chất hóa học, nồng độ CKS
và cấu trúc hiển vi của tế bào VSV. Ngoài ra cùng một CKS như nhau nhưng trong các
điều kiện khác nhau thì cơ chế cũng có thể khác nhau. Nhìn chung CKS có các cơ chế
tác động sau [22].
Ức chế tổng hợp thành tế bào:
Gồm có các nhóm kháng sinh: penicilin, baxitracin, vancomycin, xefalosporin,
rixtoxetin… [14].
Các CKS tác động theo cơ chế này đặc hiệu cao với các vi khuẩn Gram (+) bởi
chúng ức chế quá trình tổng hợp peptidoglycan, là đơn vị cấu tạo nên thành tế bào vi
khuẩn Gram (+). Các vi khuẩn Gram (-) thì không bị sự tác động của các CKS này.
Quá trình tổng hợp peptidoglucan qua trình tự các bước xúc tác của enzyme. Các CKS
β-lactam phản ứng với enzyme tổng hợp thành tế bào vi khuẩn. Trước đây, người ta
cho rằng CKS thuộc nhóm β-lactam kiềm hãm hoạt tính của transpeptidase vì nó giống
về mặt cấu trúc với phần axit amin-D-alanin của peptidoglucan mới sinh ra.
16
Những năm gần đây người ta đã mô tả về vị trí đa thụ thể trên màng tế bào chất
của vi khuẩn có liên kết cộng hóa trị với penicilin. Một số protein liên kết với penicilin
(penicilin binding protein- PBP) hoạt động như các enzyme và biểu hiện hoạt tính của
cacboxypeptidase, transpeptidase, endopeptidase, glycosylase. Vai trò chính xác của
PBP bất kể thuộc hoạt tính enzyme nào trong sự sinh trưởng và phân chia tế bào thì
cho đến nay vẫn chưa được biết rõ [2]
Ức chế tổng hợp protein
Các CKS ức chế tổng hợp protein có thể tiêu diệt được các sinh vật kể cả Gram (-) và
Gram (+) như:
Streptomixin gắn vào tiểu phần 30S của ribosome làm thay đổi hình dạng của
phần này. Do đó ảnh hưởng đến việc gắn ARN thông tin vào ribosome, làm rối loạn
việc đọc mã của ARN thông tin do đó đưa đến việc gắn sai acid amin vào chuỗi
polypeptit. Kết quả là tạo thành những loại protein bất thường [14].
Nhóm cloramphenicol tạo thành phức hợp aminoaxin-tARN, ngăn cản sự giải
phóng acid amin ra khỏi ARN vận chuyển. Cloramphenicol gắn vào tiểu phần 50S của
ribosome ức chế enzyme peptidyltransferase ngăn cản việc gắn các acid amin mới vào
chuỗi polypeptide [14].
Nhóm macrolides và lincoxinamid gắn với tiểu phần 50S của ribosome làm ngăn
cản quá trình dịch mã các acid amin đầu tiên của chuỗi polypeptide.
Phá hủy màng sinh chất:
Một số CKS làm chết tế bào bằng cách thay đổi tính thấm của màng sinh chất.
Polymixin phá vỡ lớp photpholipit cấu trúc màng sinh chất và làm cho các chất rò rỉ ra
ngoài tế bào từ đó làm tế bào chết. Các CKS nhóm polyen tác động lên thành phần
sterol và ergosterol của màng hơn là photpholipit tạo lên các lỗ trên màng làm thất
thoát các phân tử nhỏ gây chết tế bào, cho nên các CKS thuộc nhóm polyene có hiệu
quả rất lớn trong việc chống nấm.
Ức chế tổng hợp DNA:
Các CKS tác động theo cơ chế này có thể gắn với acid nucleic tạo thành phức
phân tử bất hoạt, ngăn chặn sự sao chép của các phân tử acid nucleic. Các CKS như là
actinomycine, mitomixin-D, nhóm Quinolon.
17
Ức chế cạnh tranh:
Một số CKS về mặt cấu trúc gần giống với chất trao đổi chất bình thường nên
chúng có thể tranh chấp enzyme hoặc có thể thay thế chất trao đổi, do đó ảnh hưởng
đến trao đổi chất của vi sinh vật. CKS này gọi là chất kháng sinh trao đổi chất, tác
động theo kiểu ức chế cạnh tranh.
Hình 1.6. Cơ chế tác dụng của chất kháng sinh.
1.3.5. Tình hình nghiên cứu chất kháng sinh từ vi nấm biển
Trong nước
Đa dạng sinh học biển Việt Nam đã được các nhà khoa học trong và ngoài nước
nhận định rất đa dạng và phong phú. Như vậy, hướng nghiên cứu về các hợp chất thiên
nhiên biển Việt Nam nhằm tìm kiếm các hoạt chất có hoạt tính sinh học cao là rất khả
thi, triển vọng và hứa hẹn thu được nhiều thành công.
Năm 2013 – 2015, Phạm Văn Cường et al [97] đã sàng lọc được 15 chủng VSV
biển có hoạt tính cao trong kháng lao được phân lập từ nguồn VSV đáy biển vùng
Đông bắc Việt Nam. Sau đó nghiên cứu về thành phần hóa học từ các cặn chiết dịch
ngoại bào của các chủng VSV được lựa chọn, có 82 hợp chất đã được phân lập, trong
đó có 5 hợp chất mới và 4 hợp chất mới lần đầu phân lập từ tự nhiên. Kết quả thử hoạt
tính kháng vi sinh vật kiểm định (VSVKĐ) cho thấy 24 chất thể hiện hoạt tính.
Năm 2012, Nguyễn Đình Luyện et al [18] đã phân lập từ các nguồn khác nhau
như trầm tích và các sinh vật biển thu được 38 chủng nấm biển. Kết quả cho thấy, 23
18
trong số 38 chủng có khả năng ức chế sự phát triển của các VSVKĐ bao gồm 4 chủng
có hoạt tính ức chế mạnh lên ít nhất 5 VSVKĐ bao gồm cả VK, nấm mốc và nấm
men. Đáng chú ý là cả 9 chủng nấm phân lập từ bọt biển đều có hoạt tính kháng VSV
và tất cả các chủng phân lập từ bọt biển có biểu hiện hoạt tính VSVKĐ (100%).
Ngoài nước:
Cho đến nay, hàng trăm các hợp chất đã được phân lập, nhiều hợp chất có hoạt
tính gây độc tế bào, kháng viêm, kháng vi sinh vật kiểm định. Những kết quả nghiên
cứu này đã được công bố trên các tạp chí quốc tế về hướng các hoạt chất thiên nhiên
biển, đồng thời nhiều hoạt chất đã và đang được phát triển, một số loài sinh vật biển đã
được lựa chọn thành các sản phẩm có giá trị y dược và sớm được đưa ra thị trường
phục vụ việc chăm sóc sức khỏe cộng đồng.
Trong số 23.000 chất từ VSV có hoạt tính sinh học như kháng nấm, kháng
khuẩn, kháng virus… Có đến 42% trong số đó có nguồn gốc từ các loài thuộc giới
nấm [40]. Các nghiên cứu cho thấy nấm biển có hoạt tính KS kháng được phổ rộng
các VSV [55].
Cuomo et al (1995) [46] so sánh hoạt tính KS của 1500 chủng nấm phân lập từ
biển với 1450 mẫu phân lập từ đất liền, kết luận rằng có nhiều mẫu nấm phân lập từ
biển có hoạt tính KS hơn từ đất liền.
Carsten Christophersen et al (1999) [43] nghiên cứu trên 227 chủng NS phân lập
từ biển (trong đó có Rừng ngập mặn), kết quả có 7 chủng có khả năng kháng Vibrio
parahaemoliticus, 55 chủng kháng S. aureus.
Hơn 270 hợp chất mới được tìm thấy từ nấm biển [87], và đến năm 2007 thì đã
có tổng 690 hợp chất tự nhiên phân lập từ vi nấm biển được công bố Ebel et al (2010)
[50]. Những hợp chất mới này được tạo ra chủ yếu từ các loài nấm thuộc chi
Penicillium, Aspergillus và một số loài nấm thuộc các chi ít phổ biến hơn như
Acemonium, Emericella, Epicoccum, Exophiala, Paraphaeospaeria, Phomosis và
Halarosellinia [71].